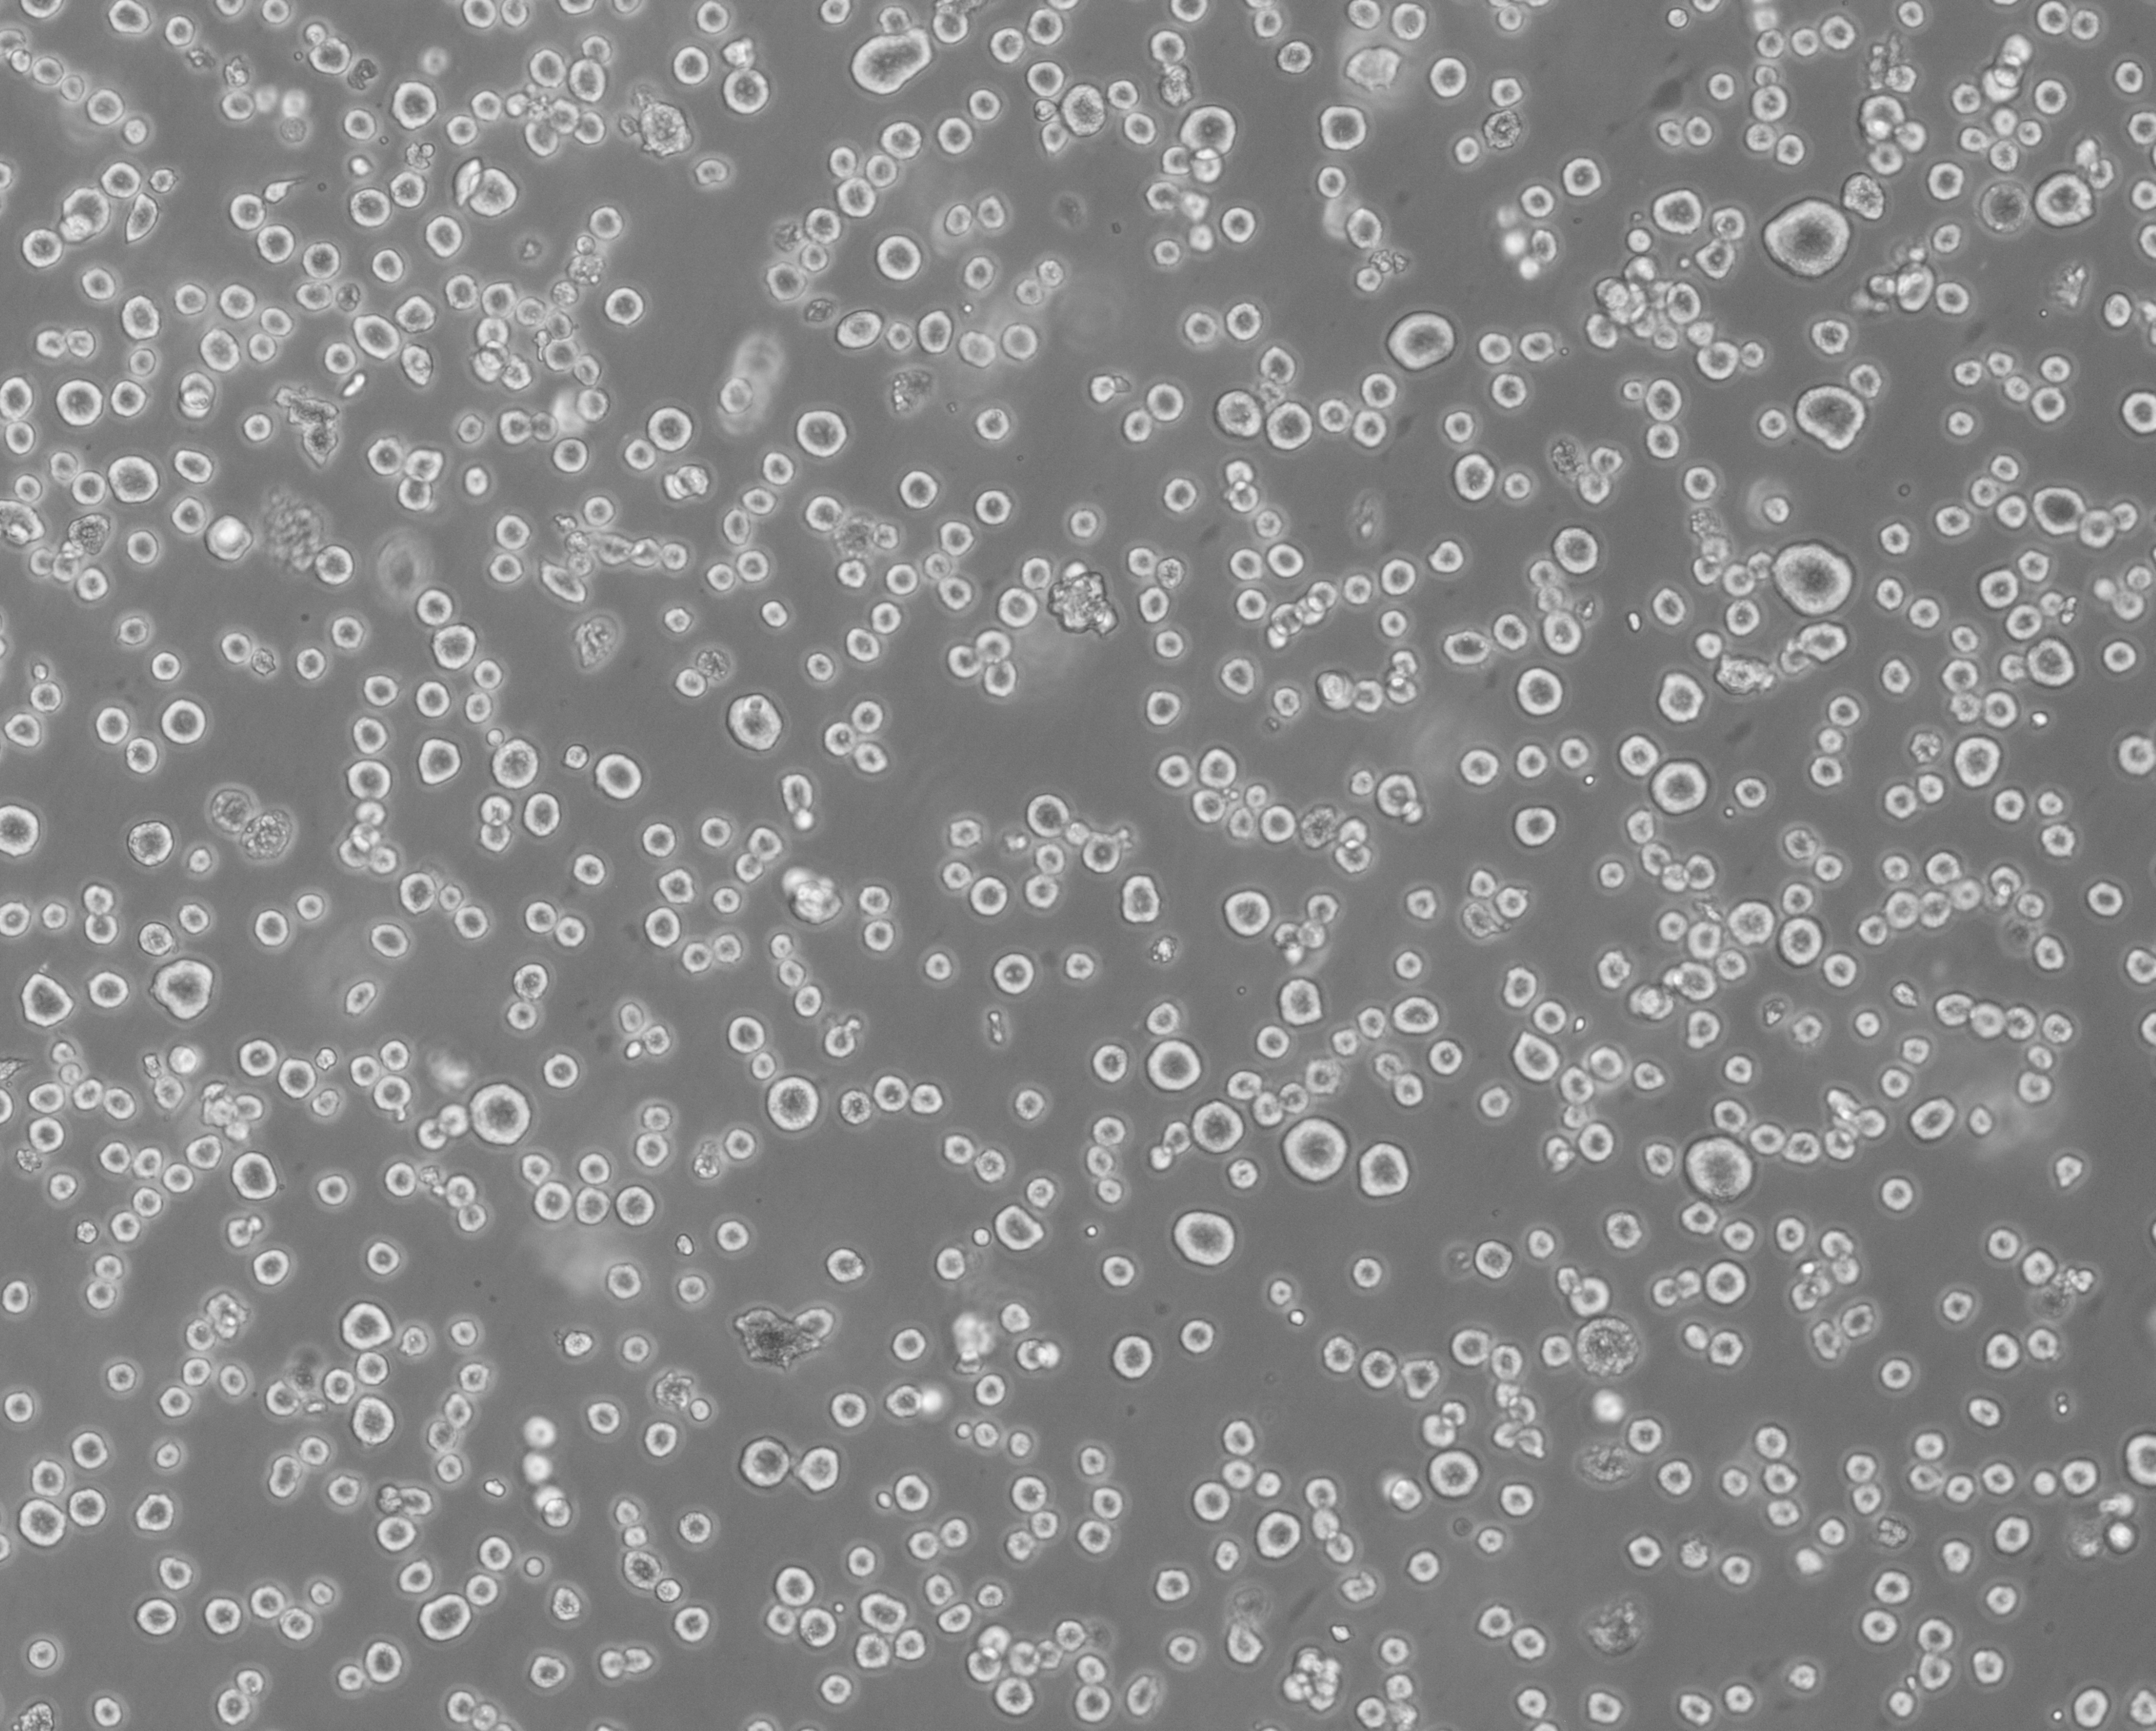
新闻图片2

武汉尚恩生物技术有限公司品牌商
6 年
手机商铺
商家活跃:
产品热度:
- NaN
- 0.2999999999999998
- 0.2999999999999998
- 2.3
- 2.3
重组人粒细胞-巨噬细胞刺激因子rhGM-CSF
¥750
推荐产品
公司新闻/正文
细胞攻略 | RPMI 8226(人多发性骨髓瘤细胞)培养教程
2567 人阅读发布时间:2023-11-27 10:30
--细 胞 基 本 信 息---
细胞名称: RPMI 8226(人多发性骨髓瘤细胞)细胞别称: RPMI 8226; RPMI.8226; RPMI8226; RPMI no 8226; 8226; RPMI 8226/S; RPMI-8226S; RPMI8226/S; 8226/S; Roswell Park Memorial Institute 8226; GM02132; GM2132; GM 2132; Simpson
细胞货号: SNL-181
生长特性: 半贴壁细胞
培养条件: 1640+10% FBS+1% P/S
培养环境: 空气,95%; 二氧化碳 (CO2),5%
细胞简介: RPMI 8226细胞是1966年从一名61岁男性浆细胞瘤患者的外周血中分离的B淋巴细胞。RPMI 8226细胞可以产生免疫球蛋白轻链,没有证据表明细胞能产生重链(细胞质型或分泌型)。RPMI 8226细胞可用于3D细胞培养、免疫学和免疫系统研究,也是一种合适的转染宿主。
细胞正常生长形态照片

RPMI 8226细胞培养注意事项
- RPMI8226细胞半贴壁圆形生长,部分悬浮圆形,传代时均可收集培养,换液时将悬浮细胞离心收集后重新接回原瓶,若贴壁细胞较多活性较好时可以不要悬浮的细胞;
- 该细胞比较脆弱,容易死亡,从而产生细胞碎片或黑点,可在换液时用PBS润洗细胞清除碎片及黑点,使用的PBS需要恢复到室温,加入时不要冲到细胞面,润洗尽量轻柔;平时在进行吹打等操作时尽量轻柔,避免细胞受损;
- 该细胞生长偏慢,需耐心培养,不频繁观察和操作,保证细胞生长环境稳定;
RPMI 8226细胞传代方法
- 准备所需的培养基、胰酶、PBS、离心管、培养瓶以及无菌枪头等;(试剂提前预热)
- 轻轻吸走培养上清,留 2-3mL 培养基轻轻吹打细胞面吹下细胞;
- 将细胞悬液转移至离心管,900rpm 离心 3-5min,弃上清;
- 加新的完全培养基轻轻重悬细胞,均匀分到新的培养瓶里;
Tips:吹打次数不宜过多,吹打力度保持轻柔,以免机械刺激造成细胞损伤。
RPMI 8226细胞冻存方法
- 配制程序性冻存液,准备相应数量冻存管并做好标记。
- 先将细胞按传代步骤获得细胞沉淀;
- 加入适量程序性冻存液轻轻重悬细胞,并将细胞悬液转移至冻存管中;
- 将冻存管放入程序性冻存盒,放入-80℃冰箱过夜;
- 转移冻存细胞至液氮保存并登记细胞保存位置。
- 液氮保存24h后建议复苏一管检测冻存细胞的活性,若活性合格即可长期保存。
- 程序性冻存液需要配合程序性冻存盒使用,若使用非程序冻存液请按产品说明书处理降温过程。
- T25培养瓶长满通常可冻存2-3管,10cm皿长满通常可冻存3-4管。
- 冻存密度低将导致复苏后细胞状态不佳。
RPMI 8226细胞复苏方法
- 提前将水浴锅预热至37℃,培养基复温至室温或37℃,离心机设置好转速;
- 将细胞从液氮罐中取出,观察管内无液氮的情况下,捏住管盖,将细胞冻存部分浸入水浴锅迅速摇晃,细胞融化至米粒大小冰块时终止水浴,融化过程不超过2min;
- 若液氮或冰箱距离细胞房较远,细胞需要放在干冰或冰盒上运送至细胞房。
- 冻存管在液氮长期保存过程中难免渗入液氮,取出细胞时震动不要过大。水浴前一定要观察管内是否存在液氮,若有液氮需静置一会待液氮完全蒸发后再水浴。做好防护,避免冻存管炸开导致受伤。
- 水浴时使用一次性PE手套包住冻存管避免直接接触水源,避免污染。
- 直接将冻存管以离心力150g(约900rpm)左右离心2min,不同离心机具体转速会有差异
- 离心完成后弃上清,用预热的培养基缓慢加入冻存管,轻柔重悬细胞后接种至培养瓶中,轻轻混匀后放入培养箱;
- 复苏24小时后观察细胞贴壁情况。
RPMI 8226细胞收货攻略
常温细胞
- 收货后,拆开外包装,用75%酒精消毒T25瓶表面,放37℃培养箱静置4h以上;
- 吸走大部分培养基并留10-12 mL,显微镜下拍照保存细胞状态照片,观察细胞密度,若细胞密度大于80%即可按比例传代(首次传代比例建议1:2),若细胞密度低于70%可以留10-12 mL继续培养至细胞密度80%以上再进行传代培养;
冻存细胞
- 细胞收货后尽快开箱检查,若干冰充足可以取出细胞迅速置于-80℃冰箱(2-3天内复苏)短期保存或液氮中长期保存,若干冰完全挥发建议立即复苏细胞并联系销售人员解决;
- 冻存细胞建议尽快复苏一管培养检查,以免超出售后期,复苏步骤参考复苏攻略;
- 复苏一管细胞出现异常及时联系销售人员,在专业技术支持的指导下进行下一步操作;
- 细胞收货出现漏液、培养瓶破损、干冰完全挥发等异常情况时,及时拍照联系销售人员;
- 尚恩生物T25瓶发货的细胞内含对应细胞的完全培养基,可以收集原装培养瓶内培养基经1500rpm离心5min后,取上清于4℃保存用于后续细胞培养;
常见问题及解决方案
细胞密度怎么计算的?
严格意义上,细胞密度需要收集细胞悬液计数细胞数量,但在实际培养过程中,并不需要为了精确控制细胞数量而消化细胞计数。因此,常用的细胞密度指细胞相对于最大生长密度的比值,贴壁细胞可以粗略的用细胞所占培养容器底面积百分比表示,即显微镜下观察培养容器底部,有细胞的区域占总区域的百分比值,当然这种表达方式受限于单个细胞生长不同密度时所占面积不同导致并不严谨,但也是相当直观、简便的表现细胞状态的一种方式。
NO.2培养过程中细胞碎片较多怎么处理?
- 细胞内的黑色颗粒是细胞外分泌泡及细胞器折光,这个属于细胞自身特性,无法清除也无法改变,大部分细胞都会有这种现象,只是不同细胞颗粒多少有区别,细胞培养体系不适应、营养缺乏、渗透压异常等均可能导致细胞内颗粒增加,建议使用合适的培养条件。
- 细胞外的黑色颗粒大部分是细胞碎片和细胞代谢产物,可以先吸走培养基后用PBS润洗清除,再加新的培养基继续培养。润洗不能清除的可以换液清洗后等细胞密度70-80%左右消化处理细胞,消化完成后加完全培养基终止消化,混匀细胞,收集细胞悬液900-1000rpm(约150g)离心3min,弃上清。再加5mL PBS重悬细胞,再离心后,用完全培养基重悬接种到新的培养皿。第二次PBS重悬是为了去除碎片,如果平时碎片比较少,传代时可以省略PBS重悬的步骤;如果碎片很多,建议PBS多洗几次。
产品推荐:
【SNL-181】RPMI 8226(人多发性骨髓瘤细胞) (STR鉴定正确)
【SNLM-181】RPMI8226细胞专用完全培养基



